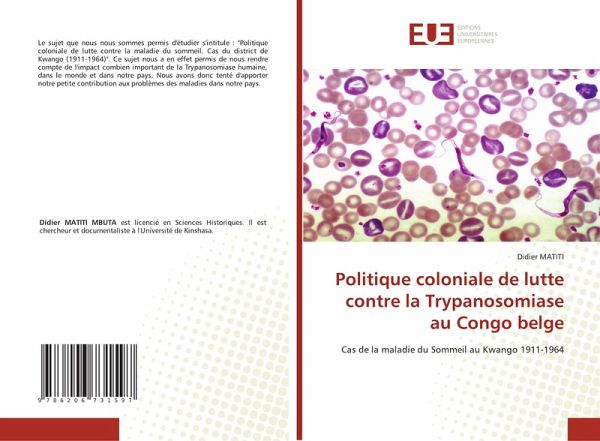

Politique coloniale de lutte contre la Trypanosomiase au Congo belge
Cas de la maladie du Sommeil au Kwango 1911-1964
Versandkostenfrei!
Versandfertig in 6-10 Tagen
28,99 €
inkl. MwSt.
PAYBACK Punkte
14 °P sammeln!
Le sujet que nous nous sommes permis d'étudier s'intitule : "Politique coloniale de lutte contre la maladie du sommeil. Cas du district de Kwango (1911-1964)". Ce sujet nous a en effet permis de nous rendre compte de l'impact combien important de la Trypanosomiase humaine, dans le monde et dans notre pays. Nous avons donc tenté d'apporter notre petite contribution aux problèmes des maladies dans notre pays.